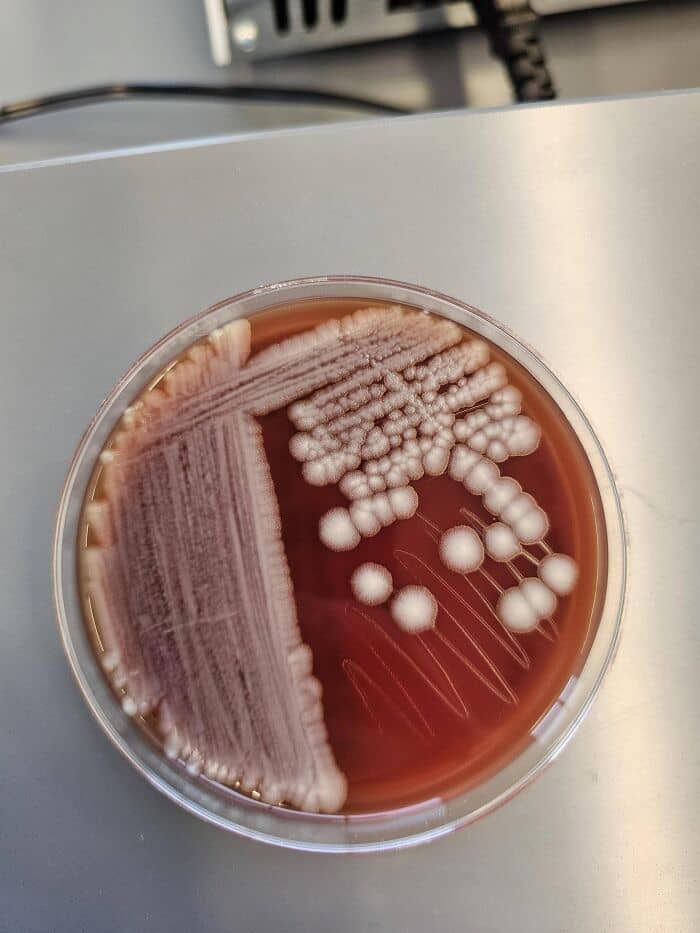

Every day, we face risk. Of course, the amount can vary: a firefighter who also does base jumping on their time off and an office worker who likes to knit lead radically different lives. But the possibility that something might go wrong is always there, whether we know it or not.
The subreddit ‘Oops, That’s Deadly’ invites everyone to post pictures of people interacting with extremely dangerous animals, plants, and other objects without realizing the threat
And based on the submissions, it’s clear that some of us have zero survival instincts.
#1 Had Both My Bathrooms Flooded With Poison Gas

Yes so I live in Turkey currently and my house has a septic tank, and apparently a government worker came by to check it because we have had way too many mosquitoes this year, and apparently there were thousands of them in there and he freaked out and pumped an unnamed horrible dense oily gas poison into my septic tank.
Bathrooms here have a drain in the floor so that when you’re cleaning it you can just squeegee the water right into the drain. And houses with septic tanks, it’s assumed that you will be using said drain on a frequent basis so that there is a water lock keeping nasty methane smells and also in this case poison gas from seeping up into your house. But I don’t use it so that s**t came right in.
An hour after this was done, my amazing teammate of a cat woke me up and let me know there was a problem. The air purifier in my sitting room was going insane, and there was this dense horrible chemical smell as I left my curtained bedroom.
I immediately aired out the area, but this stuff is so persistent that some of it hung around underneath my bed and I had to use a two fan combo to get it out in the middle of the night. Same deal for my downstairs bathroom, both my bathrooms just have one small window for ventilation and that’s it. I actually had to take care of the downstairs bathroom the next morning and the gas was still there.
So yeah, thanks for letting me ramble, hope I don’t get cancer, hope my cats don’t get cancer. I’m glad those mosquitoes are gone though, the biggest among them were a solid centimeter long and they would shake off being smacked, you have to roll them to break their wings and legs or they get back up and keep flying while flipping you off.
Here’s a photo of my 13-year-old kitty Cutie, who let me know there was something going on. I rescued him 3 years ago and I adore him so so much. The best boy
#2 A Small Mistake Right?

Prior to the Industrial Revolution, some of the biggest threats were posed by “natural” phenomena: fires could burn down not just your home but the entire city and infectious diseases weren’t yet curbed by vaccines. To avoid them, people largely relied on their own experience — as well as the experiences of others.
But as technology advanced, the risks also proliferated. Mines, factories, and other “dirty” workplaces were hotbeds of danger. And it’s not like there was a huge emphasis on safety control. But with time, states began gathering data about accidents.
According to Arwen Mohun, a history professor at the University of Delaware and author ofRisk: Negotiating Safety in American Society, it was collected to make an argument that you should pay attention to this kind of risk and that the government should step in and try to manage the risk.
The first widely collected data was about public health and about workplace accidents because those were both big political issues. The numbers were meant to shift people’s perceptions of risk.
#3 I Don’t Think That’s A Pet, You Shouldn’t Invite It Into Your Car

#4 Safe To Say I Switched Lanes Immediately After This Photo…

#5 This Person Glued Rocks And Crystals To Their Steering Wheel Airbag Effectively Making A Claymore That Points Directly At Their Face And Chest

But these days, even though data and statistics are plentiful, mass media is so hell-bent on fearmongering that it also affects what we consider to be safe and not, and suddenly, you might be having nightmares about shark attacks even if you live in a desert.
In the United States, for example, violent crimehas been plummeting for decades and air travel is as safe as it’s ever been,but in 2023, 40 percent of Americans said theyfelt unsafe walking home aloneat night — the highest rate since 1993 — and research also suggests thatGen Z sees more risk around themthan other generations.
#6 Lake Algae. Rip

#7 Seen On Fb- Luckily The Person Receiving The Fish Recognized The Issue, But The Packagers Clearly Didn’t!

#8 The “Snow” In The Wizard Of Oz Movie Was 100% Pure Asbestos

#9 Saw This Winner Parked At The Gas Station. And Yes, All 4 Looked Like This

This mismatch between what the evidence says is risky and the appropriate level of fear is what researchers call therisk perception gap.
And the interesting thing is, when our fears don’t match the evidence, the gap becomes a risk all by itself.
For instance, vaccine skeptics who fear the side effects create agreater risk of illness by forgoing the shots, since their anxieties are simply centered around the wrong thing.
#10 Finally Found Where My Lint Trap Is

Lived in my apartment for 3 years and ignorantly thought I didn’t have a lint trap in my dryer. Found out it’s under the handle on the top of it, but since it was hard to pull up, I figured it was something else and I didn’t want to break it and get management mad at me. Finally figured out that if I pull it towards me, it’ll come out. Got lucky today. So glad I got some radioactively bright red towels that clogged the inside of my dryer and proved to me that I do indeed have a lint trap I need to manually clean.
#11 Never Eat A Wild Carrots. This Is Hemlock

#12 The Guy That Mows My Lawn Sends Me Snake Pics When He Finds Them So I Can ID For Him. He Sends Me This Today

I told him he’s insane and to not pick snakes up if he can’t ID them. Also he’s extremely lucky lol. Lord have mercy the man thought it was a ball python!!!
#13 Cuddling A Copperhead, What Could Go Wrong? Stolen From A Facebook Group

Before we judge people in the pictures, wondering how dumb they must be for not realizing the amount of mess they’ve gotten themselves into, we have to understand that out internal “protection system” is pretty flawed.
A wealth of information we have available online, at our fingertips, may seem beneficial in that it allows us to learn about and protect against dangers, but there are only so many numbers we can process.
Gabriel Rubin, a professor of justice studies at Montclair State University, tells Vox we’re simply not built for all of this data, so our brain tries to keep us alive by emphasizing certain things through our emotions. It’s yelling, “This is scary. You should sway away!”
#14 Tourismts In Chernobyl, Sitting In An Excavator Claw Used After The Disaster. (It Has Deadly Levels Of Radiation)

#15 Casually Letting Your Kid Pick Up One Of The World’s Deadliest Creatures

#16 Man Thinks Animal Is Burrowing Next To His New AC Unit

It’s a sinkhole.
#17 Just Why?!?

That being said, some of us are also more susceptible to misjudging the situation.
Overconfidence is a cognitive bias where we overestimate our abilities or knowledge and incorrectly assume that we are better, wiser, or more capable than we are.
It can seriously affect our behavior and ability to predict success and accurately weigh risk.
#18 My Parents Came Back Home To This. Almost Burned Their House Down With This Concave Mirror

#19 Last Image Of Arthur Bitencourt (7) On August 3 2023 In Paraná, Brazil

The boy jumped into a pile of limestone on the side of the road. Shortly after his father took this photo, Arthur collapsed and passed away due to being poisoned from the dust.
#20 Woman Taking Selfie Gets Too Close To Bison At Yellowstone

#21 Contractors Hate This One Simple Trick

Not inevitably deadly, but I suppose a building collapse is possible, should one roll a refrigerator across the floor there or something.
Dillon Harper, PhD, a psychologist at Giles and Associates Family Psychology, says overconfidence is the brain’s way of boosting self-esteem and reducing anxiety, and it does this by focusing on past wins while minimizing or ignoring failures.
“While this positivity feels great, it can … [make] us believe we’re invincible even when we’re not. There is a fine line that oftentimes may feel like a balancing act.”
#22 Parents Wanted To Show The Cool Snail They Found While On A Vacation To Egypt

The snail in the video is a cone snail. It his highly venomous and has a stinger that carries it’s venom. With bigger ones having potent enough venom to k**l humans.
#23 This Deadly Spider’s Venom Can Give You A 5 Hour, Extremely Painful, Throbbing Erection. And K**l You And Your Family

#24 Dont Be A Josh…

#25 Lily Pollen On My Cat’s Face (Don’t Worry, She’s Okay)

Bought some roses and didn’t notice there were two lily buds in there that had not bloomed. Cat found them before I did.
#26 Oops

#27 It’s Like Physics Doesn’t Exist

#28 Daughter Found These In A Graveyard!

#29 Was Cleaning Webs Off My Porch…

#30 Best Snow On Earth

#31 Unsupported/Shifted Load

#32 I’m Allergic To Cats And He Scratched Me

#33 Found On A Metal Detecting Subreddit

#34 Imagine Smoke This

#35 Op Was Gifted A Candle Containing Minerals Which Produce Toxic Gas When Heated

#36 My Cousin Borrowed My Stepdad’s Car And Brought It Back Like This

#37 Was Posted In A Facebook Group Asking What Type (They Saved They Spider From Drowning)

#38 “It Was In Fact Not Chill”: Guy Touches Large Group Of Glaucus Atlanticus

#39 Found In A Hospital In California

#40 My Mom Made A Blanket For Her Pot

#41 My Roommate Left A Teflon Pan With Only Olive Oil On The Burner For An Hour And It Turned Blue

#42 World’s Luckiest Man And World’s Chillest Coral

#43 This Tea Is Made With A Toxic Plant That Can K**l You And It’s Being Sold On Tik Tok

#44 Is This Raccoon Rabid?. I Had To Move It And I Got Bit And Bled

#45 Hi, I’m A Dummy Who Handled An American Dagger Moth Without Knowing It Was Dangerous Lololol

#46 Here’s Me In The Neighborhood Pothole

#47 Eat First, Ask Questions Later

#48 Saw This On The Subway And Immediately Thought Of This Sub LOL. Can’t Escape The Lead Paint Glasses

#49 I Work At A Greenhouse, This Is Growing In The Courtyard. Employees Debated On Whether To Keep The Pretty Flowers Or Chop It Down…it Took Me 3 Seconds To Go, That’s Deadly

#50 Climbed My First FM Tower Last Night

#51 Parents With Toddler Move In, Deliberately Plant Datura

#52 Op Drank Mine Water

#53 Shook Off A Blanket Outdoors And This Big Girl Fell Out. Oops!

#54 Tourists In Russia Find An Old Underwater Mine And Drag It Ashore

#55 Was Cleaning My MIL’s Basement When I Came Across This

#56 My Brothers BBQ Grill (Look Closely)

My bro asked me to flip burgers at his house for his birthday party. He mentioned to “watch out for the little metal bits” as he had “already eaten a few and had to spit them out”.
#57 The Dryer Filter In The Place I Will Move In. I Am Scared Of Touching Anything Here Now

#58 I Was Chosen By A Baby Bat This Morning

#59 Handrail With Gaps And Sharp Edges

#60 Apparently “No Smoking” Is Too Hard To Read

#61 Girlfriend Complained That Her Car Was Shaking When She Went Above 40 Mph

#62 Guy Holds Raw Uranium Ore With His Bare Hands

#63 The Worst Part Of This Was Half The People In The Group Kept Saying That Snake Is A Hognose. It Is Not, That Is A Western Diamondback Rattlesnake

#64 Oh My God

#65 Man Traps Asian Hornet

#66 Need Help Identifying These Bites. Friend Just Came Back From Croatia With 20 Sores. Or Are They Not Bites??

#67 Banded Sea Krait – Middle Of Nowhere Fiji – Uneducated Me – 2012

#68 Stain Remover With A Side Of Mustard Gas! As Seen On The Inside Of My Washer Door

#69 This Is What My Manager Considers Acceptable For Our Fryers

#70 It’s All Fun And Games Until It’s Not

#71 This Lad Is Going To Introduce A New Prion Disease To Humanity

#72 This Costco Blocks All Its Emergency Exits

#73 What Happens To Potatoes After A Year In The Cellar

#74 Deadly…and Delicious

#75 I Totally Forgot I Still Had These Lithium Batteries. They’re Still Charged. Tomorrow I’m Going To Safely Dispose Of Them With A Hammer And A Couple Of Nails

#76 This Particular Way Of Frying Chicken

#77 A Shelf Full Of Enough Lead Paint To K**l 4 People

#78 Magnesium Shavings On Fire From Welding Sparks…

#79 Black Creepy Thing In My House

#80 Bomb I Found

#81 6 Mile Biking Commute Across Town With This Little One Strapped To My Back!

#82 I Didn’t Realize We Had Hallucinogenic Toads And Picked Up This Sonoran Desert Toad I Found. Didn’t Get Juiced Tho

#83 Dialysis Venous Chamber Missing A Filter That Prevents Blood Clots From Entering Patient’s Blood Stream Causing Stroke Or Heart Attack

#84 Testing Chlorine Levels In The Pool. Hibiscus Tea Was The Wrong Choice

#85 Friendly Little Dude I Caught Today

#86 My Grandmother’s Cooking Spoon From The 50’s

#87 What Could Go Wrong?

#88 Window Cracks At 38,000 Ft

#89 Pulled From Facebook

#90 Found In The Florida Everglades

#91 Why Would You Keep This In Your Yard LOL

#92 Just A Nonhemolytic Gpr From A Thumb Print… I Think I’ll Just Skip The Tube Catalase And Motility
So spill – let us sillies know!
6 6points reply Load More Replies…
I think it means that the patient they were testing was so ill with liver fibrosis that they diagnosed them easily with the most basic of tests. They didn’t need to do more expensive and invasive tests because a thumb print was enough.
9 9points reply
 Premium user. Get details. 2 months ago Report
Premium user. Get details. 2 months ago Report
They were thinking it was B. Anthrasis but didn’t read on to see if they figured out exactly what it was
1 1point reply
![]() Auntriarch Auntriarch Community Member • points posts comments upvotes FollowUnfollow 2 months ago Report
Auntriarch Auntriarch Community Member • points posts comments upvotes FollowUnfollow 2 months ago Report
Username checks out 😂
2 2points reply ![]() Ace Ace Community Member • points posts comments upvotes FollowUnfollow 2 months ago Report
Ace Ace Community Member • points posts comments upvotes FollowUnfollow 2 months ago Report
Well that’s one of you, at least.
0 0points reply
![]() Yrral Spavit Yrral Spavit Community Member • points posts comments upvotes FollowUnfollow 2 months ago Report
Yrral Spavit Yrral Spavit Community Member • points posts comments upvotes FollowUnfollow 2 months ago Report
ageeble falsier hoopy ring, camber fleeing foouts!
2 2points reply
